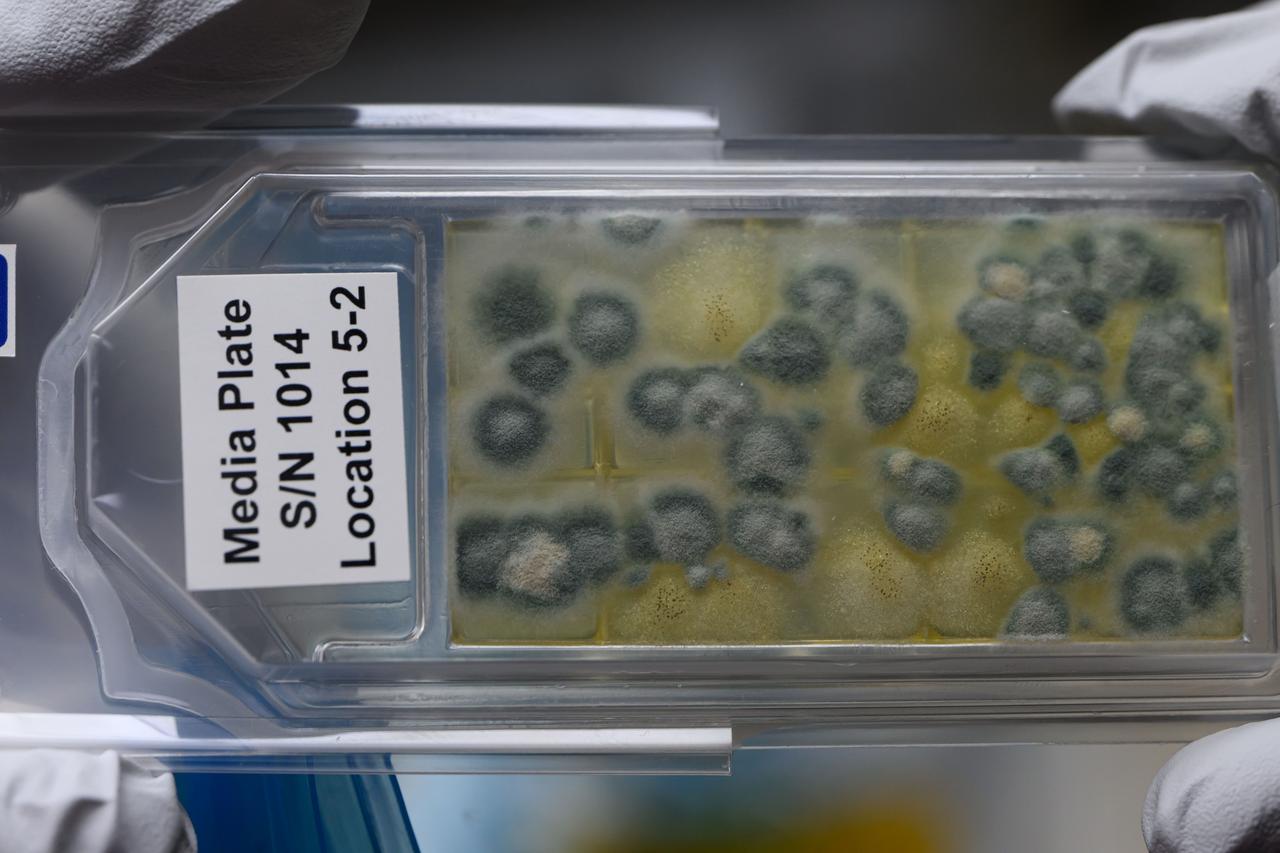
iss071e040200 (4/24/2024) --- A CS-05A: Genomic Enumeration of Antibiotic Resistance in Space (GEARS) sample media plate is shown aboard the International Space Station. The GEARS investigation surveys the space station for antibiotic resistant-organisms. Genetic analysis could show how these bacteria adapt to the space environment, providing knowledge that informs measures to protect astronauts on future long-duration missions.

This chart describes the Skylab student experiment Bacteria and Spores, proposed by Robert L. Staehle of Rochester, New York. This experiment was intended to determine the effect of the Skylab environment (particularly weightlessness) on the survival, growth rates, and mutations of certain bacteria and spores. In March 1972, NASA and the National Science Teachers Association selected 25 experiment proposals for flight on Skylab. Science advisors from the Marshall Space Flight Center aided and assisted the students in developing the proposals for flight on Skylab.

Pictures 1 and 2 show samples of Bacillus Subtillus grown during the first performance of Robert Staehle's experiment (ED-31) aboard Skylab. Pictures 3 and 4 show colonies of the same bacteria that developed during the second performance of the experiment. The experiment ED-31 was proposed by Robert L. Staehle of Rochester, New York to determine the effect of the Skylab environment (particularly weightlessness) on the survival, growth rates, and mutations of certain bacteria and spores.

Lisa Crawford, a graduate research assistant from the University of Toledo, works with Laurel Karr of Marshall Space Flight Center (MSFC) in the molecular biology laboratory. They are donducting genetic manipulation of bacteria and yeast for the production of large amount of desired protein. Photo credit: NASA/Marshall Space Flight Center (MSFC)

ISS030-E-060469 (4 Feb. 2012) --- NASA astronaut Dan Burbank, Expedition 30 commander, cleans cabin air bacteria filters in the Tranquility node of the International Space Station.

iss073e0027808 (May 10, 2025) --- NASA astronaut and Expedition 73 Flight Engineer Anne McClain works in the Kibo laboratory module's Life Sciences Glovebox processing bacteria samples before viewing them inside a 3D imaging microscope called the Extant Life Volumetric Imaging System, or ELVIS. The technology demonstration may enable applications for monitoring water quality, detecting infectious organisms on spacecraft, and researching colloids (suspensions of particles in a liquid) and microorganisms in microgravity.

Bacillus thuringiensis (Bt), a natural bacteria found all over the Earth, has a fairly novel way of getting rid of unwanted insects. Bt forms a protein substance (shown on the right) that is not harmful to humans, birds, fish or other vertebrates. When eaten by insect larvae the protein causes a fatal loss of appetite. For over 25 years agricultural chemical companies have relied heavily upon safe Bt pesticides. New space based research promises to give the insecticide a new dimension in effectiveness and applicability. Researchers from the Consortium for Materials Development in Space along with industrial affiliates such as Abott Labs and Pern State University flew Bt on a Space Shuttle mission in the fall of 1996. Researchers expect that the Shuttle's microgravity environment will reveal new information about the protein that will make it more effective against a wider variety of pests.

iss057e132633 (12/13/2018) --- A photo of the Study of the Gravity’s Effect on Bacteria (ICE Cubes Hydra-2 Bacteria Biomining) onboard the International Space Station (ISS). The ICE Cubes Hydra-2 Bacteria Biomining investigation studies the effects of microgravity on several strains of an ancient type of bacteria that does not use oxygen. The investigation is evaluating the use of these bacteria to produce methane on asteroids for use as a propellant or fuel. The Experiment Cube measures the size of the bacterial colonies in the growth chamber before and after flight.

Robert L. Staehle (center), high school student from Harley School, Rochester New York, talks with Steven Hall (advisor to Staehle) and Henry Floyd, both of the Marshall Space Flight Center (MSFC) about his experiment “Behavior of Bacteria and Bacterial Spores in the Skylab Space Environment”. He was one of the 25 winners of a contest in which some 3,500 high school students proposed experiments for the following year’s Skylab mission. Of the 25 students, 6 did not see their experiments conducted on Skylab because the experiments were not compatible with Skylab hardware and timelines. Of the 19 remaining, 11 experiments required the manufacture of equipment.

iss073e0025978 (May 9, 2025) --- NASA astronaut and Expedition 73 Flight Engineer Nichole Ayers works in the Kibo laboratory module's Life Sciences Glovebox processing bacteria samples before viewing them inside a 3D imaging microscope called Extant Life Volumetric Imaging System, or ELVIS. The technology demonstration may enable applications for monitoring water quality, detecting infectious organisms on spacecraft, and researching colloids (suspensions of particles in a liquid) and microorganisms in microgravity.

iss073e0027806 (May 10, 2025) --- NASA astronaut and Expedition 73 Flight Engineer Anne McClain works in the Kibo laboratory module's Life Sciences Glovebox processing bacteria samples before viewing them inside a 3D imaging microscope called Extant Life Volumetric Imaging System, or ELVIS. The technology demonstration may enable applications for monitoring water quality, detecting infectious organisms on spacecraft, and researching colloids (suspensions of particles in a liquid) and microorganisms in microgravity.

jsc2021e064551 (12/14/2021) --- Kaitlyn Harvey presents a 3D printed stand used to load and seal the bacteria introduction devices during assembly of the final experimental apparatus for the Determining the Efficacy of Bacteria Resistant Polymers in Microgravity (Bacteria Resistant Polymers in Space) investigation. Image courtesy of University of Idaho SPOCS Team.

jsc2021e064552 (12/14/2021) --- Preflight image of the apparatus for the Determining the Efficacy of Bacteria Resistant Polymers in Microgravity (Bacteria Resistant Polymers in Space) investigation. The University of Idaho’s Vandal Voyagers Student Payload Opportunity with Citizen Science (SPOCS) investigation focuses on bacteria-resistant materials in microgravity. Image courtesy of University of Idaho SPOCS Team.
This electron microscope image shows extremely tiny tubular structures that are possible microscopic fossils of bacteria-like organisms that may have lived on Mars more than 3.6 billion years ago. http://photojournal.jpl.nasa.gov/catalog/PIA00285

Celloulose Digesting bacteria

Data shows that elevated sialidase in bacterial vaginosis patients correlates to premature births in women. Bacterial sialidase also plays a significant role in the unusual colonization of Pseudomonas aeruginosa in cystic fibrosis patients. Crystals of Salmonella sialidase have been reproduced and are used for studying the inhibitor-enzyme complexes. These inhibitors may also be used to inhibit a trans-sialidase of Trypanosome cruzi, a very similar enzyme to bacterial sialidase, therefore preventing T. cruzi infection, the causitive agent of Chagas' disease. The Center for Macromolecular Crystallography suggests that inhibitors of bacterial sialidases can be used as prophylactic drugs to prevent bacterial infections in these critical cases.

jsc2021e064550 (12/14/2021) --- Ashley Keeley tests the long-term performance of the adhesive binding the aluminum substrates to the housing material under wet conditions for the Determining the Efficacy of Bacteria Resistant Polymers in Microgravity (Bacteria Resistant Polymers in Space) investigation. Image courtesy of University of Idaho SPOCS Team.

jsc2021e064549 (12/14/2021) --- Hannah Johnson solders the electrical circuitry that runs the Determining the Efficacy of Bacteria Resistant Polymers in Microgravity (Bacteria Resistant Polymers in Space) investigation autonomously aboard the International Space Station. Image courtesy of University of Idaho SPOCS Team.
In the center of this electron microscope image of a small chip from a meteorite are several tiny structures that are possible microscopic fossils of primitive, bacteria-like organisms that may have lived on Mars more than 3.6 billion years ago. http://photojournal.jpl.nasa.gov/catalog/PIA00283

iss060e036686 (8/19/2019) --- A view during removal of card/cube from TangoLab-2 Facility. The Effects of Microgravity on Microbial Nitrogen Fixation (Microbial Nitrogen Fixation) explores the effectiveness of two strains of nitrogen-fixing bacteria. Nitrogen is an essential element in plant growth, but plants use only reduced forms of nitrogen and much of it is produced by these bacteria. Determining whether and how nitrogen fixation occurs in space is key to successfully growing plants on future missions.
jsc2024e067093 (1/19/2024) --- Ohio University’s Mission 18 Team (Michael Lane, Victoria Swiler and Nathan Smith) examine the growth of Sphingomonas sanguinis, an ISS-derived bacteria. Their experiment, Effect of Spaceflight-Adapted Bacteria on Plant Growth and Resilience in Microgravity, is part of the Nanoracks-National Center for Earth and Space Science Education-Surveyor-Student Spaceflight Experiments Program Mission 18 to ISS (Nanoracks-NCESSE-Surveyor-SSEP).

iss071e041625 (April 24, 2024) --- NASA astronaut and Expedition 71 Flight Engineer Jeanette Epps extracts DNA samples from bacteria colonies for genomic analysis aboard the International Space Station's Harmony module. The research work may help researchers understand how bacteria adapts to weightlessness and develop ways to protect space crews and humans on Earth.

jsc2022e042490 (9/24/2021) --- Preflight image of a rack of tubes containing different cultures of bacteria to be added to sterile soil. The Dynamics of the Microbiome in Space (DynaMoS) investigation. Image courtesy of the Pacific Northwest National Laboratory.

iss066e102637 (Jan. 3, 2022) --- NASA astronaut and Expedition 66 Flight Engineer Raja Chari sequences DNA from bacteria samples using the BioMole Facility to understand the microbial environment on the International Space Station.

iss065e094111 (June 9, 2021) --- Expedition 65 Flight Engineer Thomas Pesquet of ESA (European Space Agency) works inside the Portable Glovebag for the Oral Biofilms experiment. The human research study observes how bacteria is affected by microgravity and investigates ways to counteract any potential harmful changes.

iss059e036143 (April 29, 2019) --- Expedition 59 Flight Engineer and NASA astronaut Nick Hague wears personal protection gear while working to remove bacteria filters and replacing them with charcoal filters inside the International Space Station's Tranquility module.

iss065e454862 (10/11/2021) --- A view of the Edible Foam in the Food Processor Consumables Kit aboard the International Space Station (ISS). Edible foam is made from PHA, a naturally occurring polymer synthesized by bacteria. It offers a high level of protection from isolated shocks and vibrations, which is particularly important during flights into space.

iss065e454868 (10/11/2021) --- A view of the Edible Foam in the Food Processor Consumables Kit aboard the International Space Station (ISS). Edible foam is made from PHA, a naturally occurring polymer synthesized by bacteria. It offers a high level of protection from isolated shocks and vibrations, which is particularly important during flights into space.

iss062e098352 (3/17/2020) --- A View of the ISSET-Nanoracks-Mission Discovery 4 investigation aboard the International Space Station (ISS). The Antibacterial properties of Phospholipase A2 (PLA2; bee venom) sub-investigation seeks to evaluate the antibacterial properties of PLA2 on Staphylococcus Aureus bacteria in a space environment.

iss065e454902 (10/11/2021) --- A view of the Edible Foam in the Food Processor Consumables Kit aboard the International Space Station (ISS). Edible foam is made from PHA, a naturally occurring polymer synthesized by bacteria. It offers a high level of protection from isolated shocks and vibrations, which is particularly important during flights into space.

ISS033-E-009199 (3 Oct. 2012) --- NASA astronaut Sunita Williams, Expedition 33 commander, conducts the continuing preventive inspection and cleaning of accessible Atmosphere Revitalization (AR) system bacteria filters in the Tranquility node of the International Space Station.

iss065e454878 (10/11/2021) --- A view of the Edible Foam in the Food Processor Consumables Kit aboard the International Space Station (ISS). Edible foam is made from PHA, a naturally occurring polymer synthesized by bacteria. It offers a high level of protection from isolated shocks and vibrations, which is particularly important during flights into space.

iss065e004334 (4/25/2021) --- A view of the TangoLab Facility with the Space Tango CubeLab for the Nitrogen Fixation of Leguminous Species in MicroG (Symbiotic Leguminous Nitrogen Fixation) investigation. Symbiotic Leguminous Nitrogen Fixation explores the effects of microgravity on the growth and development of legumes, plants capable of biological nitrogen fixation with symbiotic bacteria.

iss065e454854 (10/11/2021) --- A view of the Edible Foam in the Food Processor Consumables Kit aboard the International Space Station (ISS). Edible foam is made from PHA, a naturally occurring polymer synthesized by bacteria. It offers a high level of protection from isolated shocks and vibrations, which is particularly important during flights into space.

iss072e277661 (Nov. 23, 2024) --- NASA astronaut and Expedition 72 Flight Engineer Nick Hague services research hardware for the Rhodium Biomanufacturing-03 experiment inside the International Space Station's Kibo laboratory module. The investigation explores using bacteria and yeast samples as a method to potentially enable the production of food and medicine in space.

iss065e454910 (10/11/2021) --- A crewmember inspects the Edible Foam in the Food Processor Consumables Kit. Edible foam is made from PHA, a naturally occurring polymer synthesized by bacteria. It offers a high level of protection from isolated shocks and vibrations, which is particularly important during flights into space.

iss065e454849 (10/11/2021) --- A view of the Edible Foam in the Food Processor Consumables Kit aboard the International Space Station (ISS). Edible foam is made from PHA, a naturally occurring polymer synthesized by bacteria. It offers a high level of protection from isolated shocks and vibrations, which is particularly important during flights into space.

iss064e035217 (Feb. 23, 2021) --- NASA astronaut and Expedition 64 Flight Engineer Kate Rubins collects tubes containing swab samples of microbes for the 3DMM (Three-dimensional Microbial Monitoring of ISS Environment) investigation. The study analyzes and sequences the DNA from bacteria swabbed from station surfaces to understand how microbes respond at a molecular level to specific stress conditions, including altered gravity and atmospheric composition.

iss072e310952 (Dec. 3, 2024) --- NASA astronaut and Expedition 72 Flight Engineer Don Pettit processes bacteria samples in the Kibo laboratory module's Life Science Glove to understand why some pathogens are more potent in the microgravity environment. Those samples were also packed inside the SpaceX Dragon cargo spacecraft for return and analysis back on Earth. The space biology investigation uses genetic analysis techniques to identify the antibiotic resistant organisms and help researchers protect crew health on long-term space missions.

jsc2021e063274 (3/17/2021) --- Preflight imagery for the Characterizing Antibiotic Resistance in Microgravity Environments (CARMEn) experiment, part of Nanoracks Module-96. CARMEn observes how spaceflight affects the growth of a culture of two species of bacteria. The Mechanical Engineering team is pictured in the Mechanical Engineering Shop with connector piece. From left to right: Deanna Duqmaq, Alfonso Ussia, Gaurav Kulkarni, Kalpana Ganeshan.

jsc2021e019404 (1/29/2021) --- A preflight close-up image of a single aquarium bag containing eight of the squid paralarvae. The bags are connected to pumps that will inoculate the squid with the luminescent bacteria during the spaceflight. Understanding of Microgravity on Animal-Microbe Interactions (UMAMI) examines the effects of spaceflight on the molecular and chemical interactions between beneficial microbes and their animal hosts. Image courtesy of Rachel Ormsby.

iss056e100257 (Jult 29, 2018) --- Expedition 56 Flight Engineer Ricky Arnold works with a student-designed experiment using NanoRacks commercial science hardware. The study is researching the impacts of microgravity on tissue regeneration, concrete properties, antibiotics, and the growth of plant, fungi, and bacteria. The research introduces students to the principles of space science possibly leading to a career as scientists.

jsc2021e063278 (12/10/2021) --- Preflight imagery for the Characterizing Antibiotic Resistance in Microgravity Environments (CARMEn) experiment, part of Nanoracks Module-96. CARMEn observes how spaceflight affects the growth of a culture of two species of bacteria. SPOCS Project Co-Lead Swati Ravi is pictured in the Columbia University Dietrich Biological Shape and Pattern Formation Lab with prepared diluted bacterial colonies of P. aeruginosa and S. aureus.
iss071e040200 (4/24/2024) --- A CS-05A: Genomic Enumeration of Antibiotic Resistance in Space (GEARS) sample media plate is shown aboard the International Space Station. The GEARS investigation surveys the space station for antibiotic resistant-organisms. Genetic analysis could show how these bacteria adapt to the space environment, providing knowledge that informs measures to protect astronauts on future long-duration missions.

iss071e040186 (4/24/2024) --- A CS-05A: Genomic Enumeration of Antibiotic Resistance in Space (GEARS) sample media plate is shown aboard the International Space Station. The GEARS investigation surveys the space station for antibiotic resistant-organisms. Genetic analysis could show how these bacteria adapt to the space environment, providing knowledge that informs measures to protect astronauts on future long-duration missions.

iss050e011238 (11/22/2016) --- Photographic documentation of VEG-03 plants in the Veggie facility. Organisms grow differently in space, from single-celled bacteria to plants and humans. But future long-duration space missions will require crew members to grow their own food, so understanding how plants respond to microgravity is an important step toward that goal. Veg-03 uses the Veggie plant growth facility to cultivate a type of cabbage, which is harvested in orbit with samples returned to Earth for testing.

ISS027-E-022454 (5 May 2011) --- Russian cosmonaut Alexander Samokutyaev, Expedition 27 flight engineer, uses a glovebox to service the Russian Bioemulsion science payload in the Poisk Mini-Research Module 2 (MRM2) of the International Space Station. The Bioemulsion experiment is attempting to develop faster technologies for obtaining microorganism biomass and biologically active substance biomass for creating highly efficient environmentally pure bacteria, enzymes, and medicinal/pharmaceutical preparations.

iss070e129706 (March 25, 2024) --- Expedition 70 Flight Engineer and NASA astronaut Jeanette Epps installs the Advanced Space Experiment Processor-2, or ADSEP-2. The scientific device can interface with the Dragon and Cygnus cargo craft and houses cassettes that process samples for biology and physics research including cell and tissue culturing, protein crystal growth, microorganism and bacteria studies, and materials science research.

iss073e0025988 (5/9/2025) --- NASA astronaut Nichole Ayers works with the ELVIS investigation at the Life Sciences Glovebox (LSG), aboard the Kibo module of the International Space Station. Extant Life Volumetric Imaging System (ELVIS) is a microscope for 3D imaging of objects as small as bacteria, with the goal of making the technology available to anyone studying microscopic motion in space.

iss073e0118821 (May 30, 2025) --- NASA astronaut and Expedition 73 Flight Engineer Nichole Ayers conducts research operations inside the Kibo laboratory module's Life Science Glovebox aboard the International Space Station. Ayers was processing samples of deep-sea bacteria to test a specialized 3D microscope for its ability to monitor water quality, detect potentially infectious organisms, and study liquid mixtures and microorganisms in space and on Earth.

iss073e0118830 (May 30, 2025) --- NASA astronaut and Expedition 73 Flight Engineer Nichole Ayers conducts research operations inside the Kibo laboratory module's Life Science Glovebox aboard the International Space Station. Ayers was processing samples of deep-sea bacteria to test a specialized 3D microscope for its ability to monitor water quality, detect potentially infectious organisms, and study liquid mixtures and microorganisms in space and on Earth.

Martian Meteorite (ALH84001): This high resolution transmission electron microscope image is of a cast, or replica, from a chip of a Martian meteorite, labeled ALH84001, that shows the outline of what are believed to be possible microscopic fossils of bacteria-like organisms that may have lived on Mars more than 3.6 billion years ago. The tubular features in this image are less than a micrometer in size, or about 1/500th the diameter of a human hair. (JSC ref: S96-12637)

iss065e093511 (June 7, 2021) --- NASA astronaut and Expedition 65 Flight Engineer Shane Kimbrough checks out sample packs for the Oral Biofilms in Space study. The experiment observes how bacteria is affected by microgravity and investigates ways to counteract any potential harmful changes. Results could also have a positive influence for oral health on and off the Earth.

iss071e040230 (4/24/2024) --- A CS-05A: Genomic Enumeration of Antibiotic Resistance in Space (GEARS) sample media plate is shown aboard the International Space Station. The GEARS investigation surveys the space station for antibiotic resistant-organisms. Genetic analysis could show how these bacteria adapt to the space environment, providing knowledge that informs measures to protect astronauts on future long-duration missions.

iss071e040194 (4/24/2024) --- A CS-05A: Genomic Enumeration of Antibiotic Resistance in Space (GEARS) sample media plate is shown aboard the International Space Station. The GEARS investigation surveys the space station for antibiotic resistant-organisms. Genetic analysis could show how these bacteria adapt to the space environment, providing knowledge that informs measures to protect astronauts on future long-duration missions.

iss050e000489 (11/2/2016) --- View during VEG-03 plant thinning (lettuce) - Small Plant Pillow. Organisms grow differently in space, from single-celled bacteria to plants and humans. But future long-duration space missions will require crew members to grow their own food, so understanding how plants respond to microgravity is an important step toward that goal. Veg-03 uses the Veggie plant growth facility to cultivate a type of cabbage, which is harvested in orbit with samples returned to Earth for testing.

iss071e462410 (Aug. 9, 2024) --- NASA astronaut and Expedition 71 Flight Engineer Mike Barratt installs a new sample processor, also known as the Advanced Space Experiment Processor (ADSEP), inside the International Space Station's Kibo laboratory module. ADSEP can be packed with research samples and launched to space or returned to Earth aboard a Northrop Grumman Cygnus space freighter or a SpaceX Dragon cargo craft. ADSEP supports cell and tissue culturing, protein crystal growth, microorganism and bacteria studies, and materials science research.

As easy to read as a home pregnancy test, three Quantifiable Lateral Flow Assay (QLFA) strips used to test water for E. coli show different results. The brightly glowing control line on the far right of each strip indicates that all three tests ran successfully. But the glowing test line on the middle left and bottom strips reveal their samples were contaminated with E. coli bacteria at two different concentrations. The color intensity correlates with concentration of contamination.

iss065e093509 (June 7, 2021) --- NASA astronaut and Expedition 65 Flight Engineer Shane Kimbrough checks out sample packs for the Oral Biofilms in Space study. The experiment observes how bacteria is affected by microgravity and investigates ways to counteract any potential harmful changes. Results could also have a positive influence for oral health on and off the Earth.

iss070e005386 (Oct. 18, 2023) --- NASA astronaut and Expedition 70 Flight Engineer Jasmin Moghbeli uses a portable DNA detection device that can be found in laboratories and classrooms on Earth. She was identifying bacteria extracted from water samples collected aboard the International Space Station. Known as BioMole, the study is demonstrating the ability to monitor the spacecraft’s microbial environment without sending samples back to Earth for analysis.

iss064e030059 (2/8/2021) --- NASA astronaut Kate Rubins collects tubes containing swab samples of microbes for the 3DMM (Three-dimensional Microbial Monitoring of ISS Environment) investigation. The study analyzes and sequences the DNA from bacteria swabbed from station surfaces to understand how microbes respond at a molecular level to specific stress conditions, including altered gravity and atmospheric composition.

iss050e050335 (2/17/2017) --- NASA astronaut Peggy Whitson during harvesting and cleaning of VEG-03, in the Node 2. Organisms grow differently in space, from single-celled bacteria to plants and humans. But future long-duration space missions will require crew members to grow their own food, so understanding how plants respond to microgravity is an important step toward that goal. Veg-03 uses the Veggie plant growth facility to cultivate a type of cabbage, which is harvested in orbit with samples returned to Earth for testing.

iss056e100256 (Jult 29, 2018) --- Expedition 56 Flight Engineer Ricky Arnold works with a student-designed experiment using NanoRacks commercial science hardware. The study is researching the impacts of microgravity on tissue regeneration, concrete properties, antibiotics, and the growth of plant, fungi, and bacteria. The research introduces students to the principles of space science possibly leading to a career as scientists.

iss072e308289 (Dec. 2, 2024) --- NASA astronaut and Expedition 72 Commander Suni Williams displays science hardware housing bacteria and yeast samples for the Rhodium Biomanufacturing 03 study that may enable the production of food and medicine in space. Williams was in the cupola, the International Space Station's "window to the world," as the orbital outpost soared 258 miles above a cloudy Pacific Ocean off the coast of Costa Rica.

iss064e035033 (2/19/2021) --- A view at the cupola window of collects tubes containing swab samples of microbes for the 3DMM (Three-dimensional Microbial Monitoring of ISS Environment) investigation. The study analyzes and sequences the DNA from bacteria swabbed from station surfaces to understand how microbes respond at a molecular level to specific stress conditions, including altered gravity and atmospheric composition.

jsc2021e063280 (12/10/2021) --- Preflight imagery for the Characterizing Antibiotic Resistance in Microgravity Environments (CARMEn) experiment, part of Nanoracks Module-96. CARMEn observes how spaceflight affects the growth of a culture of two species of bacteria. SPOCS Project Co-Lead Swati Ravi is pictured operating an imaging microscope to observe P. aeruginosa and S. aureus bacterial biofilms in the Columbia University Dietrich Biological Shape and Pattern Formation Laboratory.
jsc2021e063277 (12/10/2021) --- Preflight imagery for the Characterizing Antibiotic Resistance in Microgravity Environments (CARMEn) experiment, part of Nanoracks Module-96. CARMEn observes how spaceflight affects the growth of a culture of two species of bacteria. Team members are pictured alongside the payload at Carleton Laboratory, where the payload’s structural integrity is tested. From left to right: Kalpana Ganeshan, Swati Ravi, Juan Zuniga, Gaurav Kulkarni, Alfonso Ussia.

iss062e087553 (3/11/2020) --- A View of the ISSET-Nanoracks-Mission Discovery 4 investigation aboard the International Space Station (ISS). The purpose of the Antibacterial properties of fly larvae extract: sub-investigation is to observe the effect of microgravity on the ability of the antibiotics found in fly larvae to eliminate E. coli bacteria. As part of the study, adipic acid, the antibacterial compound identified in fly larvae, is used and antibacterial prospects in microgravity are evaluated.

jsc2019e062137 (10/24/2019) --- Loading of the nematodes into the sample tubes. Microgravity Effect on Entomopathogenic Nematodes’ Ability to Find and Kill Insects (Module-85 Pheronym) tests the effects of microgravity on the movement and infection behavior of beneficial nematodes, which are used to control agricultural insect pests. The research looks at whether these nematodes can navigate through soil, infect insects and reproduce in space. It also looks at whether their symbiotic bacteria function normally in microgravity and has any effects on insect host physiology. Image Courtesy of: Fatma Kaplan (PI)

iss050e067347 (4/6/2017) --- A view during wick opening on each plant pillow, in the Columbus Module. Organisms grow differently in space, from single-celled bacteria to plants and humans. But future long-duration space missions will require crew members to grow their own food, so understanding how plants respond to microgravity is an important step toward that goal. Veg-03 uses the Veggie plant growth facility to cultivate a type of cabbage, which is harvested in orbit with samples returned to Earth for testing.
jsc2024e066515 (2/1/2024) --- Alma Public School students remove the sample compostable bag from garden soil following a 10-day period to measure the bag to determine the extent of decomposition. Their experiment, Will Soil Bacteria Biodegrade Compostable Plastic in Microgravity?, is part of the Nanoracks-National Center for Earth and Space Science Education-Surveyor-Student Spaceflight Experiments Program Mission 18 to ISS (Nanoracks-NCESSE-Surveyor-SSEP).

jsc2021e019402 (8/6/2016) --- Juvenile bobtail squid swimming in seawater just after hatching. The bobtail squid are born without their symbiotic microbes and must acquire them from their environment. Once the baby squid are colonized by the bacteria they gain the ability to glow in the dark and hide from their predators. Understanding of Microgravity on Animal-Microbe Interactions (UMAMI) examines the effects of spaceflight on the molecular and chemical interactions between beneficial microbes and their animal hosts. Image courtesy of Jamie S. Foster.
jsc2024e066534 (2/2/2024) --- The North Tonawanda High School student team refine their experiment and expand their knowledge on the behavior of bacteria Bacillus Thuringiensis.Their experiment, The Crystallization of the Spores of Bacillus thuringiensis in a Microgravity Environment, is part of the Nanoracks-National Center for Earth and Space Science Education-Surveyor-Student Spaceflight Experiments Program Mission 18 to ISS (Nanoracks-NCESSE-Surveyor-SSEP).

iss050e036324 (1/29/2017) --- Photographic documentation of Small Plant Pilllow (Cabbage) - Veggie-03. Organisms grow differently in space, from single-celled bacteria to plants and humans. But future long-duration space missions will require crew members to grow their own food, so understanding how plants respond to microgravity is an important step toward that goal. Veg-03 uses the Veggie plant growth facility to cultivate a type of cabbage, which is harvested in orbit with samples returned to Earth for testing.

61B-05-021 (26 Nov-3 Dec 1985) --- Payload Specialist Rodolfo Neri, representing Mexico on the STS-61B space mission aboard the Atlantis, prepares to begin one of the experiments for Mexico. Neri used a nearby 35mm camera to record plants and bacteria for various prescribed testing. Here the payload specialist has opened a stowage drawer to retrieve components of one of the tests.

iss070e129524 (March 25, 2024) --- Expedition 70 Flight Engineer and NASA astronaut Loral O'Hara shows off the Advanced Space Experiment Processor-2, or ADSEP-2. The scientific device can interface with the Dragon and Cygnus cargo craft and houses cassettes that process samples for biology and physics research including cell and tissue culturing, protein crystal growth, microorganism and bacteria studies, and materials science research.

jsc2008e152662 (12/10/2008) --- A preflight view of connectors on a Biorisk-MSV container, part of the Biorisk experiment equipment to be delivered to the ISS during the 31P flight. The Influence of Factors of the Space Environment on the Condition of the System of Microorganisms-Hosts Relating to the Problem of Environmental Safety of Flight Techniques and Planetary Quarantine (Biorisk) investigation aims to obtain new data on physical and genetic changes in bacteria and fungi typically found on spacecraft equipment, and also in various biological test objects (higher plant seeds, dormant forms of lower crustaceans) under exposure in the interior ISS compartments and on the exterior ISS surfaces.

jsc2024e038397 (6/5/2024) --- Lysozyme crystals grown with Redwire’s PIL-BOX aboard the International Space Station. This image was taken after the crystals returned to Earth in April 2024. This protein, found in bodily fluids like tears, saliva, and milk, is used as a control compound to demonstrate well-formed crystals. Lysozyme plays a vital role in innate immunity, protecting against bacteria, viruses, and fungi. The In-Space Production Application – Pharmaceutical In-space Laboratory – 02 (InSPA-PIL-02) (ADSEP-PIL-02) investigation aims to study the effect of microgravity on various types of crystals production. Image courtesy of Redwire.

jsc2008e152661 (12/8/2008) --- A preflight view of a Biorisk-MSV container, part of the Biorisk experiment equipment to be delivered to the ISS during the 31P flight. The Influence of Factors of the Space Environment on the Condition of the System of Microorganisms-Hosts Relating to the Problem of Environmental Safety of Flight Techniques and Planetary Quarantine (Biorisk) investigation aims to obtain new data on physical and genetic changes in bacteria and fungi typically found on spacecraft equipment, and also in various biological test objects (higher plant seeds, dormant forms of lower crustaceans) under exposure in the interior ISS compartments and on the exterior ISS surfaces.

jsc2019e062135 (10/24/2019) --- Dr. Karl Shiller weighs some of the material included with the nematodes tubes. Microgravity Effect on Entomopathogenic Nematodes’ Ability to Find and Kill Insects (Module-85 Pheronym) tests the effects of microgravity on the movement and infection behavior of beneficial nematodes, which are used to control agricultural insect pests. The research looks at whether these nematodes can navigate through soil, infect insects and reproduce in space. It also looks at whether their symbiotic bacteria function normally in microgravity and has any effects on insect host physiology. Image Courtesy of: Fatma Kaplan (PI)

iss060e035407 (8/13/2019) --- A view the NanoRacks-NCESSE-Gemini NanoRacks-National Center for Earth and Space Science-Gemini (SSEP Mission 13) - Part of NanoRacks Module-9 Ext. The experiments range from examinations of water filtration and purification to synthetic soil production, rust formation, antibiotic effectiveness, growth and development of microacquatic organisms, and growth of plant, fungi, and bacteria. Each was chosen from more than 3,000 entries submitted by more than 23,000 U.S., Canadian, and Brazilian students. The experiments use NanoRacks MixStix, miniature laboratories activated by space station crew and eventually returned to the student teams on Earth for analysis.

jsc2019e062136 (10/24/2019) --- Dr. Karl Shiller presents the loaded nematode tube samples. Microgravity Effect on Entomopathogenic Nematodes’ Ability to Find and Kill Insects (Module-85 Pheronym) tests the effects of microgravity on the movement and infection behavior of beneficial nematodes, which are used to control agricultural insect pests. The research looks at whether these nematodes can navigate through soil, infect insects and reproduce in space. It also looks at whether their symbiotic bacteria function normally in microgravity and has any effects on insect host physiology. Image Courtesy of: Fatma Kaplan (PI)

iss049e046023 (10/25/2016) --- NASA astronauts Shane and Kate Rubins are photographed during VEG-03 initiation in the Node 2 module. Organisms grow differently in space, from single-celled bacteria to plants and humans. But future long-duration space missions will require crew members to grow their own food, so understanding how plants respond to microgravity is an important step toward that goal. Veg-03 uses the Veggie plant growth facility to cultivate a type of cabbage, which is harvested in orbit with samples returned to Earth for testing.

iss022e026234 (1/20/2010) --- A view of Container Biorisk MSV No. 12, in the Service Module (SM) aboard the International Space Station (ISS). The Influence of Factors of the Space Environment on the Condition of the System of Microorganisms-Hosts Relating to the Problem of Environmental Safety of Flight Techniques and Planetary Quarantine (Biorisk) investigation aims to obtain new data on physical and genetic changes in bacteria and fungi typically found on spacecraft equipment, and also in various biological test objects (higher plant seeds, dormant forms of lower crustaceans) under exposure in the interior ISS compartments and on the exterior ISS surfaces.
![iss028e020313 (8/2/2011) --- A view of the Biorisk-[MSN] platform with three containers to be installed on the exterior of the Pirs Docking Compartment (DC1) during Russian EVA-29 (Extravehicular Activity). The Influence of Factors of the Space Environment on the Condition of the System of Microorganisms-Hosts Relating to the Problem of Environmental Safety of Flight Techniques and Planetary Quarantine (Biorisk) investigation aims to obtain new data on physical and genetic changes in bacteria and fungi typically found on spacecraft equipment, and also in various biological test objects (higher plant seeds, dormant forms of lower crustaceans) under exposure in the interior ISS compartments and on the exterior ISS surfaces.](https://images-assets.nasa.gov/image/iss028e020313/iss028e020313~medium.jpg)
iss028e020313 (8/2/2011) --- A view of the Biorisk-[MSN] platform with three containers to be installed on the exterior of the Pirs Docking Compartment (DC1) during Russian EVA-29 (Extravehicular Activity). The Influence of Factors of the Space Environment on the Condition of the System of Microorganisms-Hosts Relating to the Problem of Environmental Safety of Flight Techniques and Planetary Quarantine (Biorisk) investigation aims to obtain new data on physical and genetic changes in bacteria and fungi typically found on spacecraft equipment, and also in various biological test objects (higher plant seeds, dormant forms of lower crustaceans) under exposure in the interior ISS compartments and on the exterior ISS surfaces.

iss060e035405 (8/13/2019) --- A view the NanoRacks-NCESSE-Gemini NanoRacks-National Center for Earth and Space Science-Gemini (SSEP Mission 13) - Part of NanoRacks Module-9 Ext. aboard the International Space Station (ISS). The experiments range from examinations of water filtration and purification to synthetic soil production, rust formation, antibiotic effectiveness, growth and development of microacquatic organisms, and growth of plant, fungi, and bacteria. Each was chosen from more than 3,000 entries submitted by more than 23,000 U.S., Canadian, and Brazilian students. The experiments use NanoRacks MixStix, miniature laboratories activated by space station crew and eventually returned to the student teams on Earth for analysis.

Seen here are science tubes containing soil and soil microbes for the Dynamics of Microbiomes in Space (DynaMoS) experiment after they’ve been prepared for flight to the International Space Station inside the Space Station Processing Facility at NASA’s Kennedy Space Center in Florida on July 11, 2022. The DynaMoS experiment will launch on SpaceX’s 25th cargo resupply services mission to examine how microgravity affects metabolic interactions in communities of soil microbes. This will help NASA understand the function of soil microorganisms in space versus on Earth and how they can be used to enhance plant growth for crew consumption during long-duration missions to the Moon and Mars. SpaceX’s Falcon 9 rocket and Dragon spacecraft are scheduled to lift off from Kennedy’s Launch Complex 39A at 8:44 p.m. EDT on Thursday, July 14.

Pacific Northwest National Laboratory (PNNL) Scientist Yuliya Farris (left) prepares the Dynamics of Microbiomes in Space (DynaMoS) experiment inside a laboratory at the Florida spaceport’s Space Station Processing Facility on July 11, 2022. The DynaMoS experiment will launch on SpaceX’s 25th cargo resupply services mission to examine how microgravity affects metabolic interactions in communities of soil microbes. This will help NASA understand the function of soil microorganisms in space versus on Earth and how they can be used to enhance plant growth for crew consumption during long-duration missions to the Moon and Mars. SpaceX’s Falcon 9 rocket and Dragon spacecraft are scheduled to lift off from Kennedy’s Launch Complex 39A at 8:44 p.m. EDT on Thursday, July 14.

In this photo, science tubes containing bacterial cells are being prepped for cleaning as part of the Dynamics of Microbiomes in Space (DynaMoS) experiment inside the Space Station Processing Facility at NASA’s Kennedy Space Center in Florida on July 11, 2022. Once clean, the cells will be moved to a larger space for continued growth in order to generate enough biomass to inoculate the soil that will be used in the experiment. The DynaMoS experiment will launch on SpaceX’s 25th cargo resupply services mission to examine how microgravity affects metabolic interactions in communities of soil microbes. This will help NASA understand the function of soil microorganisms in space versus on Earth and how they can be used to enhance plant growth for crew consumption during long-duration missions to the Moon and Mars. SpaceX’s Falcon 9 rocket and Dragon spacecraft are scheduled to lift off from Kennedy’s Launch Complex 39A at 8:44 p.m. EDT on Thursday, July 14.

Pacific Northwest National Laboratory (PNNL) Scientist Yuliya Farris prepares the Dynamics of Microbiomes in Space (DynaMoS) experiment inside a laboratory at the Florida spaceport’s Space Station Processing Facility on July 11, 2022. The DynaMoS experiment will launch on SpaceX’s 25th cargo resupply services mission to examine how microgravity affects metabolic interactions in communities of soil microbes. This will help NASA understand the function of soil microorganisms in space versus on Earth and how they can be used to enhance plant growth for crew consumption during long-duration missions to the Moon and Mars. SpaceX’s Falcon 9 rocket and Dragon spacecraft are scheduled to lift off from Kennedy’s Launch Complex 39A at 8:44 p.m. EDT on Thursday, July 14.

Marci Garcia, a research associate at Pacific Northwest National Laboratory (PNNL), examines some of the science tubes that make up the Dynamics of Microbiomes in Space (DynaMoS) experiment inside a laboratory at the Space Station Processing Facility on July 11, 2022. The DynaMoS experiment will launch on SpaceX’s 25th cargo resupply services mission to examine how microgravity affects metabolic interactions in communities of soil microbes. This will help NASA understand the function of soil microorganisms in space versus on Earth and how they can be used to enhance plant growth for crew consumption during long-duration missions to the Moon and Mars. SpaceX’s Falcon 9 rocket and Dragon spacecraft are scheduled to lift off from Kennedy’s Launch Complex 39A at 8:44 p.m. EDT on Thursday, July 14.

Ryan McClure, scientist with Pacific Northwest National Laboratory (PNNL) prepare the Dynamics of Microbiomes in Space (DynaMoS) experiment inside a laboratory at the Space Station Processing Facility on July 11, 2022. The DynaMoS experiment will launch on SpaceX’s 25th cargo resupply services mission to examine how microgravity affects metabolic interactions in communities of soil microbes. This will help NASA understand the function of soil microorganisms in space versus on Earth and how they can be used to enhance plant growth for crew consumption during long-duration missions to the Moon and Mars. SpaceX’s Falcon 9 rocket and Dragon spacecraft are scheduled to lift off from Kennedy’s Launch Complex 39A at 8:44 p.m. EDT on Thursday, July 14.

Pacific Northwest National Laboratory (PNNL) Scientist Yuliya Farris prepares the Dynamics of Microbiomes in Space (DynaMoS) experiment inside a laboratory at the Florida spaceport’s Space Station Processing Facility on July 11, 2022. The DynaMoS experiment will launch on SpaceX’s 25th cargo resupply services mission to examine how microgravity affects metabolic interactions in communities of soil microbes. This will help NASA understand the function of soil microorganisms in space versus on Earth and how they can be used to enhance plant growth for crew consumption during long-duration missions to the Moon and Mars. SpaceX’s Falcon 9 rocket and Dragon spacecraft are scheduled to lift off from Kennedy’s Launch Complex 39A at 8:44 p.m. EDT on Thursday, July 14.

CAPE CANAVERAL, Fla. – Inside the Prototype Laboratory at NASA's Kennedy Space Center in Florida, Evan Williams, an Education intern from the University of Central Florida, prepares the experiment container for NASA's Exposing Microorganisms in the Stratosphere, or E-MIST, experiment. The container was designed and built at Kennedy. The 80-pound structure features four doors that rotate to expose up to 10 microbial samples each for a predetermined period of time in the Earth's stratosphere. The E-MIST experiment will launch on the exterior of a giant scientific balloon gondola at about 8 a.m. MST on Aug. 24 from Ft. Sumner, New Mexico. It will soar 125,000 feet above the Earth during a 5-hour journey over the desert to understand how spore-forming bacteria, commonly found in spacecraft assembly facilities can survive. Photo credit: NASA/Kim Shiflett

iss060e035409 (8/13/2019) --- A view of NASA astronaut Drew Morgan during the deactivation and/or shaking designated mixture tubes of NanoRacks-NCESSE-Gemini NanoRacks-National Center for Earth and Space Science-Gemini (SSEP Mission 13) - Part of NanoRacks Module-9 Ext. aboard the International Space Station (ISS). The experiments range from examinations of water filtration and purification to synthetic soil production, rust formation, antibiotic effectiveness, growth and development of microacquatic organisms, and growth of plant, fungi, and bacteria. Each was chosen from more than 3,000 entries submitted by more than 23,000 U.S., Canadian, and Brazilian students. The experiments use NanoRacks MixStix, miniature laboratories activated by space station crew and eventually returned to the student teams on Earth for analysis.

CAPE CANAVERAL, Fla. – Inside the Prototype Laboratory at NASA's Kennedy Space Center in Florida, Evan Williams, left, an Education intern from the University of Central Florida, and Anthony Bharrat, NASA avionics lead, prepare the experiment container for NASA's Exposing Microorganisms in the Stratosphere, or E-MIST, experiment. The container was designed and built at Kennedy. The 80-pound structure features four doors that rotate to expose up to 10 microbial samples each for a predetermined period of time in the Earth's stratosphere. The E-MIST experiment will launch on the exterior of a giant scientific balloon gondola at about 8 a.m. MST on Aug. 24 from Ft. Sumner, New Mexico. It will soar 125,000 feet above the Earth during a 5-hour journey over the desert to understand how spore-forming bacteria, commonly found in spacecraft assembly facilities can survive. Photo credit: NASA/Kim Shiflett

iss060e035415 8/13/2019) --- A view of NASA astronaut Drew Morgan during the deactivation and/or shaking designated mixture tubes of NanoRacks-NCESSE-Gemini NanoRacks-National Center for Earth and Space Science-Gemini (SSEP Mission 13) - Part of NanoRacks Module-9 Ext. aboard the International Space Station (ISS). The experiments range from examinations of water filtration and purification to synthetic soil production, rust formation, antibiotic effectiveness, growth and development of microacquatic organisms, and growth of plant, fungi, and bacteria. Each was chosen from more than 3,000 entries submitted by more than 23,000 U.S., Canadian, and Brazilian students. The experiments use NanoRacks MixStix, miniature laboratories activated by space station crew and eventually returned to the student teams on Earth for analysis.

ISS005-E-16729 (7 October 2002) --- Great Salt Lake, Utah, is featured in this image photographed by an Expedition 5 crewmember on the International Space Station (ISS). Great Salt Lake serves as a striking visual marker for crewmembers orbiting over North America. A sharp line across its center is caused by the restriction in water flow from the railroad causeway. The eye-catching colors of the lake stem from the fact that Great Salt Lake is hyper saline, typically 3-5 times saltier than the ocean, and the high salinities support sets of plants and animals that affect the light-absorbing qualities of the water. North of the causeway salinities are higher, and the water turns red from the pigments of halophilic bacteria. In the shallower corner of the lake, earthen dikes mark large salt evaporation works, which take on the jewel tones of turquoise, russet, tamber and pearl white.

ISS045e176110 (12/09/2015) --- Using the International Space Station’s robotic arm, Canadarm2 (right) NASA Flight Engineer Kjell Lindgren prepares to capture Orbital ATK’s Cygnus cargo vehicle Dec. 09, 2015. The space station crew and the robotics officer in mission control in Houston will position Cygnus for installation to the orbiting laboratory’s Earth-facing port of the Unity module. Among the more than 7,000 pounds of supplies aboard Cygnus are numerous science and research investigations and technology demonstrations, including a new life science facility that will support studies on cell cultures, bacteria and other microorganisms; a microsatellite deployer and the first microsatellite that will be deployed from the space station; several other educational and technology demonstration CubeSats; and experiments that will study the behavior of gases and liquids, clarify the thermo-physical properties of molten steel, and evaluate flame-resistant textiles.

The primary payload for Space Shuttle Mission STS-42, launched January 22, 1992, was the International Microgravity Laboratory-1 (IML-1), a pressurized manned Spacelab module. The goal of IML-1 was to explore in depth the complex effects of weightlessness of living organisms and materials processing. Around-the-clock research was performed on the human nervous system's adaptation to low gravity and effects of microgravity on other life forms such as shrimp eggs, lentil seedlings, fruit fly eggs, and bacteria. Materials processing experiments were also conducted, including crystal growth from a variety of substances such as enzymes, mercury iodide, and a virus. The Huntsville Operations Support Center (HOSC) Spacelab Payload Operations Control Center (SL POCC) at the Marshall Space Flight Center (MSFC) was the air/ground communication channel used between the astronauts and ground control teams during the Spacelab missions. Featured are activities in the SL POCC during STS-42, IML-1 mission.

jsc2020e003405 (10/30/2019) --- A preflight view of BioServe’s Fluid Processing Apparatus (FPA) in a three-chamber configuration. From bottom to top: sterile growth medium and 1 cm2 material coupon, bacteria in stasis (inoculum), and fixative for controlled experiment termination. FPAs were used to house the bacterial component of this experiment, where six different materials were tested. The Characterization of Biofilm Formation, Growth, and Gene Expression on Different Materials and Environmental Conditions in Microgravity (Space Biofilms) investigation characterizes the mass, thickness, structure, and associated gene expression of biofilms that form in space by analyzing different microbial species grown on different materials. Biofilm formation can cause equipment malfunction and human illnesses, and could be a serious problem on future long-term human space missions.